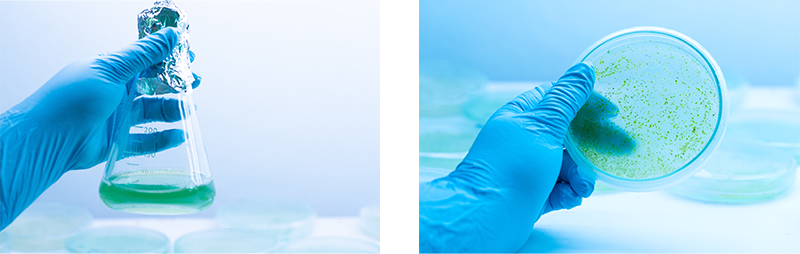
Beta Alg-Strain Development

Strain Development
There are 2 approaches to improve performance of microalgae as cell factories. The first is to manipulate metabolism of microalgae by physical factors such as light regimes and chemical composition of culture medium. The other approaches are genetic manipulation applied by metabolic engineering or random mutations. Metabolic engineering applications aim to alter metabolic pathways by manipulation of genetic background of microalgae such as knock-out or silencing of targeted genes, overexpression or alien genes transfer through genetic transformation into algae cells. Although, there is some regulatory issues to be used genetically modified organisms in food and cosmetic industries, it has been extensively used to improve biosynthesis of economically important metabolites.
Random mutagenesis has been used as a nature-based genetic manipulation approaches as alternative to genetic transformation to improve performance of cell factories. Algae cells are exposed to physical (such as UV exposure) or chemicals mutagenesis to create variety of genetic and phenotypic diversity of mutant. Then mutants have been screened for the cell showing the most desired phenotypic properties.
We have been studying to develop super astaxanthin accumulated H. pluvilalis strains by random mutagenesis and genomic transformation application in our laboratories. We have successfully applied both genetic manipulation techniques and the metabolic toolbox such as next-generation sequencing and transcriptomics to create our own hyper astaxanthin accumulated strains in our laboratory.

Genomic transformation of Claminomonas reinhardtii for astaxanthin biosynthesis